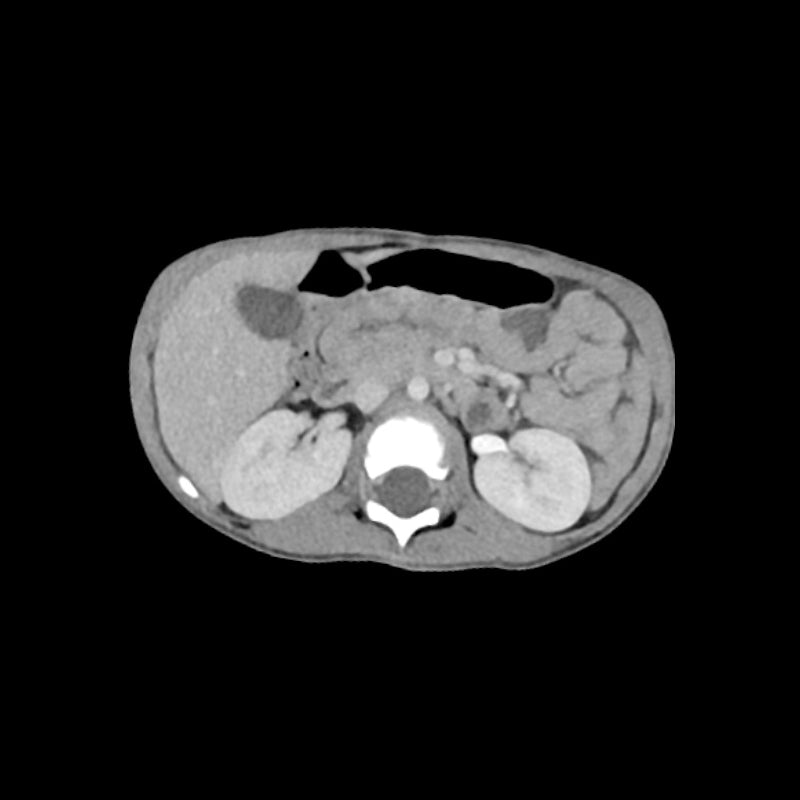

Your shopping cart is empty.
3-Year-Old Child Torso Phantom for CT Scan and X-Ray Training
Item # PX-58-04-LRequest a quote for pricing
Need an estimate?
Click Add To Quote

-
by
A trusted GT partner -
1-Year Warranty
Provided by manufacturer -
Gov't pricing
Available upon request
3-Year-Old Child Torso Phantom for CT Scan and X-Ray Training
This phantom simulates a 3-year-old child's contrast medium enhanced thorax, abdomen and pelvis in portal venous phase. It covers the sixth cervical vertebra to the perineum.
The phantom can be used in CT (including CBCT) and X-ray imaging to evaluate and optimize imaging performance and post-processing applications, including AI-enabled applications. It is also suited for training purposes.
The phantom provides a detailed and realistic simulation of soft and bone tissue. Air voids including those of the lungs are filled with a cellulose-polymer composite of approx. -160 HU.
- Size: Approx. 24 x 14 x 40 cm
- Weight: Approx. 6.3 kg
- Base material: Cellulose-polymer composite
- Optimal tube voltage: 100 kVp – (adaptable upon request)
- Realistic simulation of vasculature, bone and soft tissues, including:
- Lungs
- Heart
- Liver
- Gallbladder
- Pancreas
- Spleen
- Adrenals
- Kidneys
- Stomach
- Small intestine
- Colon
- Bladder

- The phantom is made of a cellulose-polymer composite material with properties similar to hardwood. If handled carefully, it will last a long time.
- The phantom is coated with a protective layer. If the protective layer is undamaged, the phantom can be cleaned using a damp cloth (water or mild detergent)
- Protect from direct sunlight.
- Maintain a storage temperature of 10°C to 30°C. If the phantom is exposed to temperatures below -10°C or above 45°C, it can be severely damaged.
- The phantom is not equipped for dose measurements with dosimeters and it is not suited for material characterization with dual energy CT.
- The phantom is not certified as medical device.
- Air voids are filled with cellulose-polymer composite of approx. -160 HU.
Made by PhantomX and sold by GTSimulators.
GTSimulators by Global Technologies
PhantomX Authorized Dealer
- Size:Approx. 24 x 14 x 40 cm
- Weight:Approx. 6.3 kg

-
General indications:
- Phantoms are manufactured of a cellulose-polymer composite material with similar properties to hardwood. If treated carefully, they will last for a long period.
- The phantoms are coated with a protective layer. If the protective layer is unharmed, the phantoms can be cleaned using a damp cloth (water or mild detergent).
- Protect from direct sunlight.
- Maintain a storage temperature of 10 °C to 30 °C.
- If the phantom is exposed to temperatures below -10 °C or above 45 °C, it can be seriously damaged.
- The phantom is not equipped for dose measurements with dosimeters and it is not suited for material characterization with dual energy CT.
- Air voids are filled with cellulose-polymer composite of approx. -80 HU.

Request a quote for pricing